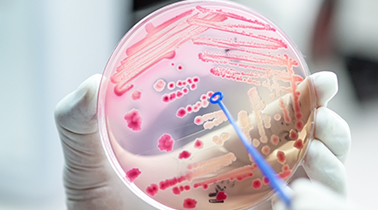
Microbiology

Careers in Food Science
- Learn About Food Science
- Careers in Food Science
- Food Facts
- Why Food Science Matters
Careers in Food Science
- Learn About Food Science
- Careers in Food Science
- Food Facts
- Why Food Science Matters
Food Quality & Microbiology

Food Engineering

Product Development

Food Chemistry

Sensory Science

Food Marketing & Sales
What Kind of Income Can You Make in Science of Food Fields?
Food scientists typically earn salaries competitive with other science and engineering degrees. Most have successfully found a job or earned admission to graduate school months after graduation.
According to IFT’s 2022 Career and Compensation Survey Report, the median salary for professionals working in the science of food is $110,000. Food science graduates entering the field received a median salary starting at $77,000.
Below is a sampling of science of food career titles and their average salaries.

$175,000
Director of Research
$90,300
Food Scientist/Technologist
$87,000
Food Chemist
$92,500
Nutritionist
$123,000
Food Engineer
$119,601
Food Marketing & SalesDay in the Life of a Food Scientist
What is it really like to be a food scientist? What do food scientists do each day? What kinds of things do they think about? Learn more about what it’s like to be a food scientist in the words of people who do it every day.
Food Science: Making Food Fun
IFT and Disney Consumer Products (DCP) partnered to raise the visibility of food science careers and the innovative potential of the profession to develop healthy and nutritious foods. Check out what a food scientist does at Disney.
Amy DeJong & Maya Warren: Ph.D. Students in Food Science
IFT Student Association members Amy DeLong and Maya Warren show us what life is like for Ph.D. students in food science at the University of Wisconsin-Madison.
Cory Bryant: FDA and Food Safety
IFT member Cory Bryant, Ph.D., CFS, shows us how the USFDA works with other countries to improve food safety so that future generations have access to a safe and abundant global food supply.
Fu-hung Hseih: Food Science Professor
University of Missouri Professor Fu-hung Hseih, Ph.D., CFS, talks about his work developing a soy-based food product that is sold in grocery stores nationwide and why he enjoys being a food scientist.
Brian Thane: Food Packaging Professional
IFT member Brian Thane, Director of Aseptic Technology at Tetra Park, talks about providing aseptic packaging to 170 countries, the interesting and rewarding aspects of his job, and how it contributes to the food science profession.
Michele Perchonok: Former Food Scientist at NASA
Follow IFT member Michele Perchonok, former Advanced Food Technology Manager at NASA, and members of the food science team as they guide us through their work in the Space Food Systems Laboratory and describe their role in conceptualizing and preparing food for successful missions in space.

